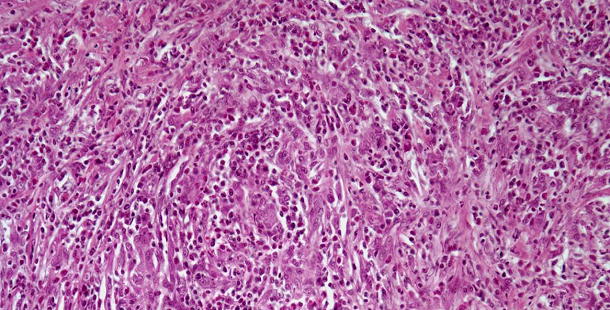

A 58-year-old man presents with symptoms of dysuria and a prostate biopsy is performed. What is your diagnosis?
A 58-year-old man presents with symptoms of dysuria and a prostate biopsy is performed. Looking at the histopathology slide below, what is your diagnosis?
What is your diagnosis?